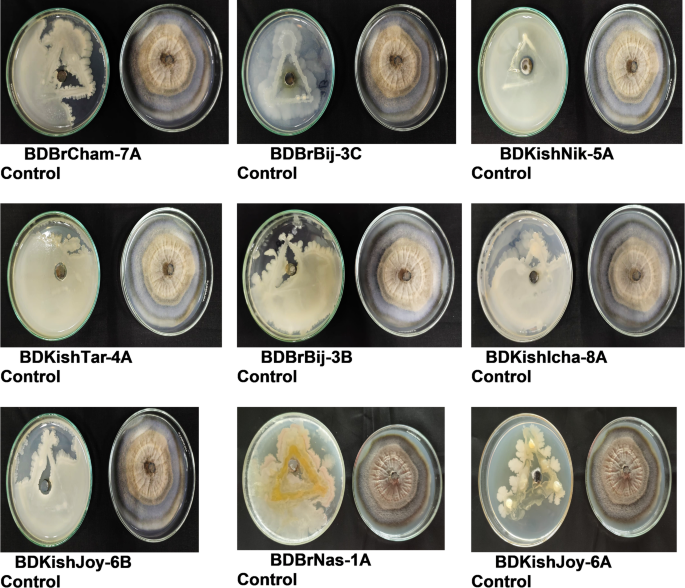
figure 2
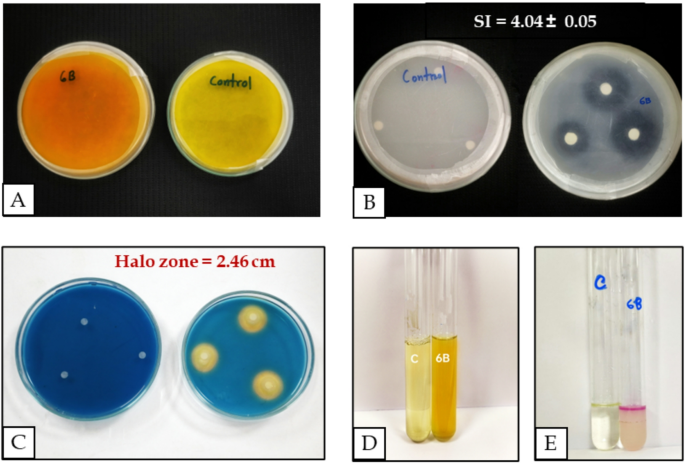
figure 4

Abstract
Rice blast, caused by Magnaporthe oryzae, is a persistent threat to rice production in Bangladesh, particularly in the haor (wet-land basin) region, where up to 80% yield loss occurs annually. This study aimed to explore the potential of an endophytic bacterium, Bacillus velezensis BDKishJoy-6B, for promoting growth and enhancing blast tolerance in rice cultivars commonly grown in this vulnerable agro-ecosystem. Fifteen isolates of P. oryzae were collected from haor regions and characterized morphologically and for pathogenicity. The most virulent isolate, KSH01 (GenBank: PQ269871.1), was selected for pathogenicity assays. Antagonistic endophytic bacteria were isolated from rice roots and screened for plant growth-promoting traits. The most effective isolate, BDKishJoy-6B, was identified as B. velezensis (GenBank accession: PQ770697.1). This strain was applied to two rice cultivars (US-2 and BRRI Dhan34) via seed priming, seedling priming, and combined treatments. Growth parameters, yield traits, defense gene expression (OsPOD, OsPAL1, OsPR5), and antioxidant enzyme activities (SOD, POD, APX, PPO, MDA) were assessed under artificial disease pressure. B. velezensis BDKishJoy-6B significantly enhanced rice growth and yield under blast stress, especially in BRRI Dhan34. Notably, seedling priming showed the highest upregulation of defense genes and antioxidant activities, correlating with reduced disease symptoms and increased biomass accumulation. Seedling priming with B. velezensis BDKishJoy-6B offers a promising bio-management strategy for controlling rice blast by modulating host antioxidant and defense pathways, with potential application in haor-based rice production systems.
Similar content being viewed by others
Introduction
Rice (Oryza sativa L.) is one of the most important staple crops globally, feeding over three billion people. It serves as a primary source of calories for a significant proportion of the world’s population, with an average per capita consumption of about 57 kg annually1. Bangladesh ranks as the third-largest producer of rice, contributing significantly to the global rice supply2. In Bangladesh, rice is grown across three primary seasons- Aus, Aman, and Boro that covers 11.7 million hectares, accounting for 77% of the total cropped area2. Rice plays a critical role in ensuring food security, but its production is severely threatened by various biotic and abiotic factors, particularly plant diseases.
Among the diseases, rice blast caused by Magnaporthe oryzae, also known as Pyricularia oryzae, is considered the most destructive fungal pathogen, causing significant yield losses worldwide. Rice blast can affect all parts of the rice plant, including leaves, nodes, stems, and panicles, often leading to severe reductions in crop yield. This disease is highly prevalent in Bangladesh, especially during the Boro season, where it can result in losses ranging from 28% to as high as 80% in severe cases3.
The haor wetlands in northeastern Bangladesh contribute about 15% of the country’s annual rice production (and roughly 25% of its Boro rice), making them vital for food security but also rendering them especially vulnerable to rice blast disease, which can cause substantial losses in the Boro crop grown there4. Rice blast typically begins as small, spindle- or eye-shaped lesions on leaves that have a whitish or grayish center and a reddish-brown to dark brown margin5. The disease causes both direct yield losses through poor grain filling and indirect losses through the degradation of plant health and vigor6.
Traditionally, rice blast has been managed through the use of chemical fungicides and resistant rice cultivars. Fungicides such as tricyclazole, azoxystrobin, and benomyl have been commonly used to control the spread of rice blast, effectively managing the disease in many cases6. However, the reliance on fungicides has raised concerns about environmental pollution, the development of fungicide-resistant strains of M. oryzae, and the impact of chemical residues on human health7. The overuse of fungicides not only aggravates these problems but also leads to the degradation of soil quality, increased pesticide resistance, and contamination of water bodies8. Furthermore, excessive pesticide use has been linked to poisoning and long-term health risks, particularly in developing countries where pesticide management practices may be inadequate. Given these limitations, there is a growing need to explore sustainable and environmentally friendly alternatives to chemical control.
In response to these challenges, biological control using beneficial microorganisms has emerged as a promising alternative to chemical pesticides. Biological control agents (BCAs), particularly plant growth-promoting bacteria (PGPB), offer a sustainable approach to managing plant diseases, including rice blast. Endophytic bacteria, which reside within plant tissues without causing harm, have been shown to possess significant biocontrol potential. These bacteria suppress pathogen growth through various mechanisms such as competition for nutrients and space, production of antimicrobial metabolites, and induction of systemic resistance in plants9. Additionally, endophytic bacteria promote plant growth by enhancing nutrient uptake, producing plant hormones, and improving stress tolerance10.
Among the many beneficial bacteria, Bacillus velezensis has gained attention for its broad-spectrum biocontrol activity and plant growth-promoting abilities. B. velezensis is a Gram-positive bacterium known for producing a range of antimicrobial compounds, including lipopeptides such as surfactin, fengycin, and iturin, which exhibit strong antifungal and antibacterial properties11. These compounds enable B. velezensis to suppress a variety of phytopathogens, including M. oryzae, the causal agent of rice blast. Moreover, B. velezensis has been shown to enhance plant growth through mechanisms such as nitrogen fixation, phosphate solubilization, and production of phytohormones like indole acetic acid (IAA), which promote root development and overall plant health12.
Several studies have demonstrated the effectiveness of B. velezensis as a biocontrol agent against M. oryzae. For instance, B. velezensis has been shown to inhibit the growth of M. oryzae both in vitro and in vivo, and its application significantly reduces disease severity and enhances rice yield13. The bacterium’s ability to induce systemic resistance in plants further enhances its potential as a biocontrol agent, as it triggers plant defense mechanisms that provide protection against subsequent pathogen attacks14. The application of B. velezensis in seed treatment or biopriming has been particularly effective in enhancing plant resilience against fungal diseases, suggesting its potential for sustainable Fusarium disease management in maize15.
Biopriming, the application of beneficial microorganisms to seeds or seedlings before planting, has gained popularity as an effective and sustainable strategy to manage plant diseases and improve crop productivity. In rice, biopriming with B. velezensis has been shown to enhance plant growth, increase antioxidant enzyme activity, and improve the expression of defense-related genes in response to pathogen attack16. By promoting systemic acquired resistance (SAR), bioprimed rice plants exhibit increased tolerance to fungal infections such as rice blast, resulting in healthier plants and higher yields17. The potential of B. velezensis in biopriming is attributed to its ability to modulate plant immune responses and improve plant health through the production of antioxidants and other bioactive compounds. Several studies have highlighted the role of B. velezensis in enhancing antioxidant enzyme activity, including peroxidase (POD), catalase (CAT), and superoxide dismutase (SOD), which play crucial roles in mitigating oxidative stress during pathogen attack16,18. By enhancing the plant’s natural defense systems, B. velezensis not only protects against pathogens but also improves overall plant vigor and productivity.
Given the significant challenges posed by rice blast and the promising potential of B. velezensis as a biocontrol agent, this study aims to (i) characterize M. oryzae strains from major haor regions and assess their pathogenicity on rice (ii) identify endophytic bacteria from rice plants in the haor regions, evaluating their antagonistic activity against M. oryzae and (iii) assess the plant growth-promoting traits of selected B. velezensis strains and evaluate the impact of biopriming with B. velezensis on antioxidant enzyme activity and defense-related gene expression in rice. Although the role of B. velezensis as a biocontrol agent has been widely reported, its performance in the unique haor agroecosystem of Bangladesh remains unexplored. This study not only establishes the dual functionality of the endophyte BDKishJoy-6B in both blast suppression and growth promotion but also provides novel evidence of its ability to transcriptionally modulate rice defense and antioxidant pathways. Furthermore, by directly comparing seed, seedling, and foliar priming, we highlight seedling biopriming as the most effective strategy, offering a practical and eco-friendly approach for blast management in haor-based rice systems.
Materials and methods
Experimental sites and period
Field and laboratory experiments were conducted between April and November 2024 at the Department of Plant Pathology, Bangladesh Agricultural University, and the Plant Pathology Division, Bangladesh Institute of Nuclear Agriculture (BINA), Mymensingh, Bangladesh. Pot experiments were carried out in the net house of BINA.
Sample collection
Collection of blast-infected plant samples
Neck blast-infected panicles showing characteristic black lesions at the base of the panicle were collected during the Boro season (2023–2024) from 15 haor locations across Brahmanbaria and Kishoreganj districts. Samples were wrapped in sterile paper bags, labeled, and transported to the laboratory for fungal isolation (Supplementary Table 1).
Collection of healthy root samples
Healthy root samples (n = 37) were collected from 37 locations across eight upazilas in the haor region. Roots were washed and stored in sterile zipper bags and preserved at − 20 °C until further analysis 9Supplementary Table 2).
Isolation and characterization of Pyricularia oryzae (anamorph)
Fungal isolation and purification
Blast-infected rachis tissues (3–5 cm) were incubated on moist blotter paper at room temperature (25 ± 2 °C) for 24 h to stimulate sporulation of P. oryzae. Single conidia were transferred to potato sucrose agar (PSA; 20 g sucrose, 200 g potato infusion, 15 g agar per liter) and incubated at 25 °C under alternating 12 h light/dark cycles19. Pure cultures were maintained on PSA slants at 4 °C.
Morphological characterization
Colony color, surface texture, and radial growth were recorded after 5, 10, and 15 days. Conidial shape, size, and septation were examined under a compound microscope at 400× magnification.
Pathogenicity test
For pathogenicity assessment, 21-day-old seedlings were spray-inoculated with conidial suspension (1 × 10⁵ conidia mL⁻¹) prepared in 0.02% Tween-20. Inoculated plants were covered with black polyethylene sheets for 24 h to ensure high humidity and incubated in the net house. Disease incidence (DI) and percent disease index (PDI) were recorded at 7 days post-inoculation following20.
Molecular identification
Genomic DNA was extracted using the Wizard® Genomic DNA Purification Kit (Promega, USA). ITS regions were amplified using ITS1 (5′-TCCGTAGGTGAACCTGCGG-3′) and ITS4 (5′- CTGTTGGTTTCTTTT CCTCCGC-3′) primers21. and sequenced. Sequences were aligned using CLUSTALW and phylogenetic trees were constructed in MEGA v11 using the neighbor-joining method with 1000 bootstrap replicates.
Isolation and screening of endophytic bacteria
Isolation and preservation
Surface-sterilized root tissues were macerated in sterile phosphate-buffered saline and serially diluted up to 10⁻⁶. Dilutions were spread on nutrient agar (NA; 5 g peptone, 3 g beef extract, 15 g agar per liter) and incubated at 37 °C for 24 h. Distinct colonies were purified by streaking and preserved in 30% glycerol at − 80 °C.
Antagonistic activity
Dual culture assays were performed on potato dextrose agar (PDA; 20 g dextrose, 200 g potato infusion, 15 g agar per liter). A 5 mm plug of P. oryzae KSH01 was placed at the center of the plate, while a 5 mm bacterial disc (24 h old culture on NA) was placed 2 cm away from the fungal plug. Plates were incubated at 24 ± 2 °C for 7 days22. Radial growth of the fungus was measured every 5 days, and the percent inhibition of radial growth (PIRG) was calculated using Vincent’s formula23.
Plant growth-promoting traits
Indole-3-acetic acid (IAA) production
Bacterial isolates were inoculated into tryptone broth supplemented with 0.1% L-tryptophan and incubated at 35 °C, 120 rpm, for 48 h. After centrifugation, 2 mL supernatant was mixed with 2 mL Salkowski’s reagent (1 mL 0.5 M FeCl₃ in 50 mL 35% HClO₄). Development of a pink color after 30 min indicated IAA production24.
Siderophore production
Siderophore activity was tested on chrome azurol S (CAS) agar plates25. Development of a yellow-orange halo zone around colonies indicated positive results.
Phosphate solubilization
Isolates were spot-inoculated on Pikovskaya’s agar and incubated at 28 °C for 7 days. Solubilization index was calculated as the ratio of the total halo diameter to colony diameter26. Please look carefully the below equation. Consider the final corrected manuscript.
Ammonia production
Bacterial cultures grown in peptone water (5 mL) were supplemented with 0.5 mL Nessler’s reagent. A brown to yellow coloration indicated ammonia production27.
HCN production
Bacteria were grown on King’s B medium supplemented with 4.4 g L⁻¹ glycine. Whatman filter paper soaked in 0.5% picric acid solution (in 2% Na₂CO₃) was placed inside the lid. A change from yellow to orange-brown indicated HCN production28.
Molecular identification of bacteria
Genomic DNA was extracted, and the 16 S rRNA gene was amplified using universal primers 27 F and 1492R29. PCR products were sequenced, and BLAST analysis was performed against the NCBI database. Phylogenetic analysis was conducted in MEGA v11 using the neighbor-joining method with 1000 bootstrap replicates.
Biopriming and pot trials
Seed biopriming
Surface-sterilized rice seeds were soaked in bacterial suspension (1 × 10⁷ CFU mL⁻¹, prepared in 1% carboxymethyl cellulose) for 12 h at room temperature with gentle shaking30. Treated seeds were air-dried before sowing.
Seedling biopriming
Twenty-one-day-old rice seedlings were immersed in bacterial suspension (1 × 10⁷ CFU mL⁻¹) for 12 h. Immediately after treatment, seedlings were transplanted into pots (20 cm diameter, 4 kg sterilized soil).
Foliar spraying
At 21 days post-transplantation, seedlings were sprayed with bacterial suspension (1 × 10⁷ CFU mL⁻¹) until runoff.
Experimental setup
Pot trials were arranged in a completely randomized design (CRD) with three replications. Treatments included: T1: Seed priming, T2: Seedling priming, T3: Seed + seedling priming, and T4: Control. Two rice varieties (US-2 and BRRI dhan34) were used. In this study, BRRI dhan34 was considered as popular aman variety for haor areas and US-2 was considered as universal susceptible check variety. Pots were inoculated with P. oryzae @ 1 × 107 CFU/ml at 21 days post-transplantation.
Disease assessment
Disease incidence (DI) and percent disease index (PDI) were recorded at 7-, 14-, and 21-days post-inoculation using standard scales31,32. The area under disease progress curve (AUDPC) was calculated according to Simko and Piepho (2012)33.
Enzymatic and molecular responses
Biochemical assays
Leaf samples were collected 48 h post-inoculation for antioxidant enzyme assays:
-
Peroxidase (POD): measured following Anushree et al. (2017)34.
-
Superoxide dismutase (SOD): assayed according to Kumar et al. (2012)35.
-
Polyphenol oxidase (PPO): determined by the method of Mayer et al. (1965)36.
-
Ascorbate peroxidase (APX): activity measured following Nakano and Asada (1981)37.
-
Malondialdehyde (MDA): content measured as an indicator of lipid peroxidation (Chen & Zhang, 2016)38.
Gene expression analysis
Total RNA was extracted using the SV Total RNA Isolation System (Promega). First-strand cDNA synthesis was performed with the GoScript™ kit. Quantitative PCR was conducted with gene-specific primers for OsPOD, OsPAL1, and OsPR5, normalized against OsActin16. Reactions were run with SYBR Green in a StepOnePlus Real-Time PCR system (Applied Biosystems). Relative gene expression was calculated using the 2⁻ΔΔCt method.
Statistical analysis
All data were analyzed using R software (v4.3.0). Two-way ANOVA was performed for treatment and cultivar effects, followed by Fisher’s LSD test at p < 0.05. Data are presented as mean ± standard deviation.
Results
Isolation and morphological characterization of Pyricularia oryzae (anamorph)
Fifteen Pyricularia oryzae isolates were obtained from blast-infected rice rachis collected from various haor regions of Bangladesh. After 3–4 days of incubation on moist blotter paper, the fungus sporulated on rachis tissues, producing brown to black structures. Single-spore isolation followed by sequential sub-culturing on potato sucrose agar (PSA) ensured the purity of isolates. Microscopic examination confirmed typical conidial morphology of P. oryzae, consisting of 2–3 celled, pyriform or pear-shaped spores.
Colony morphology
The 15 isolates exhibited significant morphological diversity on PSA medium. Colony colors were grouped into six distinct categories: greyish, greyish black, greyish white, brownish grey, blackish, and whitish. Surface textures were either smooth (7 isolates) or rough (8 isolates), indicating diversity in surface mycelial development. These variations suggest possible adaptive responses or inherent genetic differences among isolates originating from different agroecological zones (Table 1).
Conidial morphology
Conidial characteristics were highly variable across isolates. Based on shape, four morphological types were observed: fusoid, fusoid with tapering ends, ventricose, and ovoid. Spore sizes also varied among isolates, forming five size groups. KSH01, NAS03, and NIK02 exhibited the largest conidia ((23.44–26.80) × (8.08–8.5) µm), while TARL01 and NIK01 showed the smallest. Such variability in conidial morphology and size is often associated with pathogenic fitness and environmental adaptability (Table 2).
Radial growth
All isolates were grown on PSA for 15 days, and radial mycelial growth was measured at 5-day intervals. KSH01 exhibited the fastest growth rate (7.9 cm at 15 DAI), whereas TARL01 was the slowest (3.59 cm). These differences in radial expansion reflect variability in growth kinetics, potentially linked to virulence (Table 3).
Pathogenicity assessment of P. oryzae isolates
The virulence potential of the 15 isolates was evaluated on the susceptible rice cultivar under net-house conditions. Small lesions appeared by 3–5 DAI and gradually developed into spindle-shaped lesions with grey centers. Disease incidence (DI) varied from 10% to 70%, while percent disease index (PDI) ranged from 6% to 48% (Table 4).
Isolate KSH01 showed the highest pathogenicity, with DI and PDI of 70% and 48%, respectively. On the contrary, TARL01 and NIK01 were the least virulent. Given its high virulence and rapid growth, KSH01 was selected for molecular identification and in vitro antagonism assays.
Molecular identification and phylogenetic positioning of KSH01
The internal transcribed spacer (ITS) region of KSH01 amplified a 545 bp product. BLAST analysis confirmed 99% identity with multiple P. oryzae isolates (Table 5). Phylogenetic tree construction using the neighbor-joining method placed KSH01 in a distinct clade closely related to POIIRR 4, suggesting geographic or functional divergence (Fig. 1).
Isolation and antagonistic activity of endophytic bacteria
From 46 endophytic bacterial isolates derived from rice root tissues, dual culture assays were performed to assess antifungal potential against KSH01 (Table 6). Eleven isolates demonstrated > 89.75% inhibition of fungal growth at 15 DAI (Fig. 2). Among them, BDKishJoy-6B achieved the highest inhibition (93.75%), followed by BDBrCham-7 A (93.13%) and BDBrBij-3B (92.29%) (Fig. 3). Radial growth of KSH01 was significantly suppressed by these isolates, indicating strong mycostatic activity.
Functional screening for plant growth promoting traits
The top 11 antagonistic isolates were subjected to a series of biochemical assays for plant growth promotion:
Indole-3-Acetic acid (IAA): Four isolates tested positive for IAA production, notably BDKishJoy-6B, which produced a pronounced cherry-red layer (Table 7; Fig. 4). IAA production is essential for root development and stress tolerance.
Siderophore production: Eight isolates exhibited yellow halo zones on CAS agar, with BDKishJoy-6B producing the largest zone (2.46 cm) (Table 7, Nine and Fig. 4). Siderophore production helps in iron chelation and limits pathogen access to this essential micronutrient.
Phosphate solubilization: Six isolates solubilized phosphate on Pikovskaya’s agar. BDKishJoy-6B had the highest solubilization index (4.04), further enhancing its utility in promoting nutrient availability (Tables 7 and 8; Fig. 4).
Ammonia and HCN production: Ten isolates produced ammonia, and eight produced HCN, both of which contribute to nutrient cycling and pathogen suppression. BDKishJoy-6B tested positive for both traits (Table 7; Fig. 4).
Based on overall performance, BDKishJoy-6B was selected for further net-house and molecular assays.
Safety and molecular characterization of BDKishJoy-6B
The hypersensitivity test on tobacco leaves confirmed that BDKishJoy-6B is non-pathogenic to non-host plants (Supplementary Fig. 1). Molecular identification via 16 S rRNA sequencing revealed 99% similarity with Bacillus velezensis (Accession PQ770697.1). Phylogenetic analysis grouped it closely with other B. velezensis strains, validating its identity and biosafety (Fig. 5).
Gene expression of defense-related markers
Quantitative RT-PCR analysis evaluated three defense-related genes (OsPOD, OsPAL1, OsPR5) in BRRI dhan34 and US-2 cultivars under treatments T1 (seed biopriming), T2 (seedling biopriming), and T3 (foliar spraying) (Fig. 6). BRRI dhan34 under T2 showed the highest upregulation: OsPOD (69.95-fold), OsPAL1 (25.33-fold), and OsPR5 (239.96-fold). In US-2, gene expression was comparatively lower or suppressed. This suggests that BDKishJoy-6B enhances plant immunity through transcriptional modulation of defense genes (Table 9).
Antioxidant enzyme activity
BDKishJoy-6B application significantly increased antioxidant enzyme activity in both cultivars. POD activity reached 1123.56 U/min/g FW in BRRI dhan34 (T2). Similarly, SOD (4.87 U/mg protein), APX (1.26 µmol/min/mg protein), and PPO (1.26 ΔAbs/min/g FW) were highest in T2-treated BRRI dhan34. In contrast, MDA levels, indicative of lipid peroxidation, were lowest in T2 (3.66 nmol/g FW), confirming reduced oxidative stress (Fig. 7).
Disease suppression and biocontrol efficacy in pot experiments
Disease incidence (DI), percent disease index (PDI), and area under disease progress curve (AUDPC) were significantly reduced under BDKishJoy-6B treatments (Figs. 8 and 9). At 21 DAI, BRRI dhan34 treated with T2 showed the lowest DI (23.33%) and PDI (19.33%), with an AUDPC of 406. In contrast, untreated control (T4) exhibited 86.67% DI and 76% PDI with an AUDPC of 1596. Biocontrol efficacy reached a peak of 74.85% under T2 treatment.
Enhancement of agronomic traits
Yield-contributing parameters were positively influenced by BDKishJoy-6B. In BRRI dhan34, T2 treatment resulted in the highest 1000-grain weight (15.13 g), shoot length (147 cm), root length (39.44 cm), and root dry weight (58.79 g). Similar improvements were noted in US-2, though to a lesser extent (Table 10). These enhancements indicate that BDKishJoy-6B promotes growth and yield through multiple synergistic mechanisms.
Effect of BDKishJoy-6B on the suppression of disease incidence of rice blast disease in pot experiment at 7, 14 and 21 days after inoculation (DAI), Here, T1 = Seed biopriming with Bacillus velezensis BDKishJoy-6B, T2 = Seedling biopriming with Bacillus velezensis BDKishJoy-6B, T3 = Foliar spraying with Bacillus velezensis BDKishJoy-6B, T4 = Control, V1 = US-2 (susceptible check), V2 = BRRI Dhan34.
Discussion
The production of rice is severely challenged by fungal pathogens, among which Magnaporthe oryzae (syn. Pyricularia oryzae), the causal agent of rice blast, is the most devastating. In Bangladesh, particularly in the Haor agroecosystem, yield losses can reach up to 80% during the Boro season39. Given the limitations of chemical control, biological approaches, particularly using endophytic bacteria, have emerged as promising alternatives. This study explored the potential of endophytic Bacillus velezensis BDKishJoy-6B as a dual-function bioagent—both as a plant growth promoter and as a modulator of defense mechanisms in rice against M. oryzae.
Fifteen P. oryzae isolates collected from the Haor region displayed marked cultural and morphological diversity. Variability in colony pigmentation, radial growth, and spore characteristics was consistent with earlier reports40. The isolate KSH01 showed the highest growth rate and pathogenicity, confirming its virulence and suitability for downstream biocontrol assays. Such diversity reflects the adaptive versatility of M. oryzae under the waterlogged Haor ecosystem, underscoring the need for broad-spectrum, sustainable management strategies. In the present study, ITS sequence analysis was used to confirm the identity of the most virulent isolate, KSH01, as Pyricularia oryzae. While ITS is a well-established fungal barcode marker, it offers limited resolution at intra-species level. Future studies should therefore employ multi-locus sequence typing (MLST) using additional housekeeping genes such as TEF1-α, β-tubulin, and calmodulin to better resolve genetic diversity and evolutionary relationships among P. oryzae populations.
Among 46 bacterial isolates screened, BDKishJoy-6B emerged as the most effective antagonist, inhibiting > 93% of P. oryzae KSH01 in dual culture. This aligns with previous reports that B. velezensis produces antifungal metabolites such as surfactins, iturins, and fengycins, which disrupt fungal membranes and interfere with appressorium formation41,42. In addition, BDKishJoy-6B expressed multiple plant growth-promoting traits (IAA, siderophore, phosphate solubilization, ammonia, and HCN production). These attributes enhance nutrient availability and indirectly strengthen host resistance43,44. Its particularly high phosphate solubilization and siderophore production are notable, given the nutrient-deficient, flood-prone soils of the Haor region45,46.
Seedling biopriming with BDKishJoy-6B activated key defense genes (OsPOD, OsPAL1, and OsPR5), all central to the salicylic acid-mediated systemic acquired resistance pathway (Park et al., 2012). The striking 239-fold upregulation of OsPR5 in T2 treatment mirrors the responses reported for other B. velezensis strains16. Upregulation of OsPOD and OsPAL1 further demonstrates enhanced ROS detoxification and lignification processes47,48,49. These results confirm that B. velezensis can transcriptionally prime rice immunity.
Antioxidant enzyme activity was also strongly enhanced. Significant increases in SOD, POD, PPO, and APX levels, coupled with reduced MDA content, point to an improved redox balance in treated plants. Such modulation of oxidative stress responses is consistent with previous findings50,51,52. This suggests that BDKishJoy-6B provides dual protection: activating systemic resistance while mitigating oxidative damage during pathogen challenge.
Integration of molecular, physiological, and phenotypic data confirmed that BDKishJoy-6B substantially suppressed blast disease. Seedling biopriming reduced incidence to 6.67% and achieved a biocontrol efficacy of 74.85%, outperforming seed priming and foliar spray. This agrees with earlier studies showing superior disease suppression through root colonization and early endophyte establishment16,53,54. Colonization at the seedling stage may also prevent early root infection by M. oryzae55.
Importantly, BDKishJoy-6B not only restricted disease but also improved agronomic performance, with significant gains in 1000-grain weight, shoot and root length, and root biomass. This dual benefit parallels findings with other Bacillus strains56,57. Its capacity to simultaneously promote growth and suppress disease positions BDKishJoy-6B as a valuable component of climate-resilient rice production, particularly in vulnerable Haor ecosystems. However, while pot experiments are promising, further field-scale validation remains essential.
Conclusion
This study demonstrated that endophytic Bacillus velezensis BDKishJoy-6B exhibits a dual role in rice by enhancing plant growth and conferring tolerance against Magnaporthe oryzae through the activation of defense-related and antioxidant genes. The strain not only promoted morphological and physiological improvements but also triggered molecular responses associated with induced systemic resistance. These findings highlight the potential of BDKishJoy-6B as a sustainable alternative to chemical inputs for managing rice blast and improving crop productivity especially in the haor region of Bangladesh. Further large-scale field evaluations under diverse agroecological conditions are essential to validate its efficacy and stability. Additionally, formulation development, compatibility with existing crop management practices, and multi-pathogen bioefficacy testing should be prioritized to facilitate its commercialization as a broad-spectrum bioinoculant.
Data availability
The datasets used and/or analysed during the current study available from the corresponding author on reasonable request.
References
Shew, C. et al. Global rice consumption trends. Rice Sci. 26, 162–168 (2019).
BBS. The Yearbook of Agricultural Statistics of Bangladesh (Bangladesh Bureau of Statistics, Government of the People’s Republic of Bangladesh, 2022).
Simkhada, K. & Thapa, R. Rice blast: a major threat. Turk. J. Agric. Food Sci. Technol. 10, 147–157 (2022).
IRRI. World wetland day: irri’s role in preserving bangladesh’s Haor wetland ecosystem. Rice Today (2021).
Nabina, N. & Kiran, B. A review of blast disease of rice in Nepal. J. Plant. Pathol. Microbiol. 11, 12 (2020).
Kato, H. Rice blast disease. Pestic Outlook. 12, 1–5 (2001).
Suprapta, D. Microbial antagonists as biocontrol agents. J. Int. Soc. Southeast. Asian Agric. Sci. 18, 1–8 (2012).
Dante, F. S., Octavio, G. D. & Roberto, C. M. A review on fungal-based biopesticides and biofertilizers production. Ecotoxicol. Environ. Saf. 283, 116945 (2024).
Ganie, S. A., Bhat, J. A. & Devoto, A. The influence of endophytes on rice fitness under environmental stresses. Plant. Mol. Biol. 109, 447–467 (2022).
Kamran, M. et al. Endophyte-mediated stress tolerance in plants. Cells 11, 3292 (2022).
Nadya, A. et al. Bacillus velezensis R22 inhibits fungal phytopathogens. Biotechnol. Biotechnol. Equip. 38, 1–15 (2024).
Hanen, D. et al. Potential of a novel endophytic Bacillus velezensis in tomato growth promotion and protection against verticillium wilt disease. Biol. Control. 139, 104092 (2019).
Chen, Z. et al. Isolation and evaluation of Bacillus velezensis ZW-10 as a potential biological control agent against Magnaporthe oryzae. Biotechnol. Biotechnol. Equip. 34, 714–724 (2020).
Xuan, Z. et al. Bacillus velezensis HN-2 as antiviral agent. Front. Plant. Sci. 15, 1403202 (2024).
Figueiredo, J. E. F. et al. Bacillus velezensis CNPMS-22 as biocontrol agent of pathogenic fungi and plant growth promoter. Front. Microbiol. 5, 1522136 (2025).
Chen, Z. et al. The antagonistic mechanism of Bacillus velezensis ZW10 against rice blast disease: evaluation of ZW10 as a potential biopesticide. PLoS One. 16, e0256807 (2021).
Amruta, N. et al. Bio-priming of rice seeds with novel bacterial strains for management of seedborne Magnaporthe oryzae L. Plant. Physiol. Rep. 24, 507–520 (2019).
Su, L. et al. Mechanism of Bacillus velezensis JLU-1 against M. oryzae. J. Agric. Food Chem. 72, 19657–19666 (2024).
Hayashi, N. et al. Protocols for sampling diseased specimens and evaluation of blast disease in rice. JIRCAS Work Rep. 63, 17–33 (2009).
Someya, N. et al. Induced resistance to rice blast by Serratia marcescens B2. J. Gen. Plant. Pathol. 68, 177–182 (2002).
White, T. J., Bruns, T., Lee, S. & Taylor, J. Amplification and sequencing of fungal rRNA genes. In PCR Protocols, 315–322 (1990).
Anisah, P. H., Zurai, R. & Haliatur, R. Antagonistic potential of endophytic bacterial consortia against sheath blight pathogen in rice. IOP Conf. Ser. : Earth Environ. Sci. 1469, 012019 (2025).
Vincent, J. M. Distortion of fungal hyphae in the presence of certain inhibitors. Nature 159, 850 (1927).
Murthy, K., Rompicherla, R. & Deshmukh, K. Pseudomonas as plant growth promoter. Indo Am. J. Pharm. Res. 4, 5447–5467 (2014).
Alexander, D. B. & Zuberer, D. A. Use of Chrome azurol S reagents to evaluate siderophore production by rhizosphere bacteria. Biol. Fertil. Soils. 12, 39–45 (1991).
Edi-Premono, M., Moawad, A. M. & Vleck, P. L. G. Effect of phosphate-solubilizing Pseudomonas Putida on the growth of maize and its survival in the rhizosphere. Indones J. Agric. Sci. 11, 13–23 (1996).
Gautam, S. et al. Potential of Bacillus amyloliquefaciens for biocontrol of bacterial canker of tomato incited by clavibacter Michiganensis ssp. Michiganensis. Microb. Pathog. 130, 196–203 (2019).
Castric, K. F. & Castric, P. A. Method for rapid detection of cyanogenic bacteria. Appl. Environ. Microbiol. 45, 700–702 (1983).
Frank, J. A. et al. Critical evaluation of two primers commonly used for amplification of bacterial 16S rRNA genes. Appl. Environ. Microbiol. 74, 2461–2470 (2008).
Das, S. et al. Seed biopriming with potential bioagents influences physiological processes and plant defense enzymes to ameliorate sheath blight induced yield loss in rice (Oryza sativa L). World J. Microbiol. Biotechnol. 39, 136 (2023).
Goto, K. & Yamanaka, S. Studies on the race of blast fungus. Bull. Fac. Agric. Utsunomiya Univ. 7, 27–71 (1968).
James, W. C. Assessment of plant diseases and losses. Annu. Rev. Phytopathol. 12, 27–48 (1974).
Simko, I. & Piepho, H. P. Area under disease progress stairs. Phytopathology 102, 381–389 (2012).
Anushree, P. U., Naik, R. M., Satbhai, R. D., Gaikwad, A. P. & Nimbalkar, C. A. Differential biochemical response of rice (Oryza sativa L.) genotypes against rice blast (Magnaporthe oryzae). Cogent Biol. 2, 1264162 (2017).
Kumar, A. et al. Engineering a thermo-stable superoxide dismutase functional at sub-zero to > 50°C. Sci. Rep. 2, 387 (2012).
Mayer, A. M., Harel, E. & Shaul, R. B. Assay of catechol oxidase. Phytochemistry 5, 783–787 (1965).
Nakano, Y. & Asada, K. Hydrogen peroxide scavenging in spinach chloroplasts. Plant. Cell. Physiol. 22, 867–870 (1981).
Chen, T. & Zhang, B. Measurements of proline and malondialdehyde content and antioxidant enzyme activities in leaves of drought-stressed cotton. Bio-Protocol 6, e1913 (2016).
BRRI. Annual Report 2020–21. Bangladesh Rice Research Institute, Gazipur, Dhaka. (2021).
Chinmayee, S. et al. Morphological and molecular characterization of Magnaporthe oryzae causing rice blast disease in Odisha. Oryza 55, 467–472 (2018).
Zhang, R. S. et al. Iturins from Bacillus velezensis Jt84 in biocontrol of rice blast disease. Biol. Control. 174, 105001 (2022).
Liu, X. et al. Cell wall integrity in Magnaporthe oryzae is weakened by proteins secreted by Bacillus licheniformis BL06. Biol. Control. 157, 104582 (2021).
Puri, A., Padda, K. P. & Chanway, C. P. Nitrogen-fixation by endophytic bacteria. In Nitrogen in Agriculture (2018).
Etesami, H. Enhanced phosphorus fertilizer use efficiency with microorganisms. In Nutrient Dynamics for Sustainable Crop Production (ed Meena, R.) (Springer, Singapore, (2020).
Masum, M. M. I. et al. Halotolerant Bacillus amyloliquefaciens group in biocontrol of rice brown Stripe pathogen. J. Appl. Microbiol. 125, 1852–1867 (2018).
Liu, Y. et al. Siderophore produced by Bacillus velezensis YL2021 for control of rice sheath blight and blast. Phytopathology 114, 2491–2501 (2024).
Yang, Y. et al. Bacillus siamensis B-612 suppresses rice blast fungus. Int. J. Mol. Sci. 24, 8513 (2023).
Gao, Y. et al. Antagonistic activity against rice blast disease and elicitation of host defense response capability of an endophytic Streptomyces Albidoflavus OsiLf-2. Plant. Pathol. 69, 259–271 (2020).
Bowles, D. J. Defense-related proteins in higher plants. Annu. Rev. Biochem. 59, 873–907 (1990).
Rais, A. et al. Bacillus spp. Enhance antioxidant defense enzymes in rice. PLoS One. 12, e0187412 (2017).
Li, R. et al. Woody lesion mimic mutant conferring resistance to Alternaria alternata in Birch. Sci. Rep. 7, 11308 (2017).
Thanwisai, L., Siripornadulsil, W. & Siripornadulsil, S. Kosakonia Oryziphila NP19 as plant growth promoter and biopesticide. Sci. Rep. 14, 17944 (2024).
Lei, L. Y. et al. Biological control of Magnaporthe oryzae using natively isolated Bacillus subtilis G5. Front. Microbiol. 14, 1264000 (2023).
Sultana, R. et al. Pseudomonas mosselii PR5 improving rice growth. BMC Plant. Biol. 24, 10–30 (2024).
Sesma, A. & Osbourn, A. E. Developmental processes of rice leaf blast pathogen. Nature 431, 582–586 (2004).
Zhou, H. et al. Efficacy of Bacillus tequilensis JN-369 in biocontrol of rice blast. Biol. Control. 160, 104652 (2021).
Rais, A. et al. Antagonistic Bacillus spp. Reduce blast incidence and increase yield. Microbiol. Res. 208, 54–62 (2018).
Acknowledgements
We gratefully acknowledge the City Bank Limited, Bangladesh for awarding the grants (Grants no. 2023/14/Other).
Funding
This research was supported by The City Bank Limited, Bangladesh under the project number: 2023/14/Other.
Author information
Authors and Affiliations
Contributions
S.A. - Material preparation, data collection and analysis, First draft of Manuscript ; S.C. , M.M.H. and T.R.- Material preparation, data collection and analysis, manuscript review M.A.R.K.- Manuscript review and making final draft of manuscript, supervision.
Corresponding author
Ethics declarations
Competing interests
The authors declare no competing interests.
Additional information
Publisher’s note
Springer Nature remains neutral with regard to jurisdictional claims in published maps and institutional affiliations.
Supplementary Information
Below is the link to the electronic supplementary material.
Rights and permissions
Open Access This article is licensed under a Creative Commons Attribution-NonCommercial-NoDerivatives 4.0 International License, which permits any non-commercial use, sharing, distribution and reproduction in any medium or format, as long as you give appropriate credit to the original author(s) and the source, provide a link to the Creative Commons licence, and indicate if you modified the licensed material. You do not have permission under this licence to share adapted material derived from this article or parts of it. The images or other third party material in this article are included in the article’s Creative Commons licence, unless indicated otherwise in a credit line to the material. If material is not included in the article’s Creative Commons licence and your intended use is not permitted by statutory regulation or exceeds the permitted use, you will need to obtain permission directly from the copyright holder. To view a copy of this licence, visit http://creativecommons.org/licenses/by-nc-nd/4.0/.
About this article
Cite this article
Akter, S., Chakraborty, S., Haque, M.M. et al. Endophytic Bacillus velezensis BDKishJoy 6B promotes rice growth and enhances resistance to Magnaporthe oryzae. Sci Rep 15, 45618 (2025). https://doi.org/10.1038/s41598-025-29919-x
Received:
Accepted:
Published:
Version of record:
DOI: https://doi.org/10.1038/s41598-025-29919-x